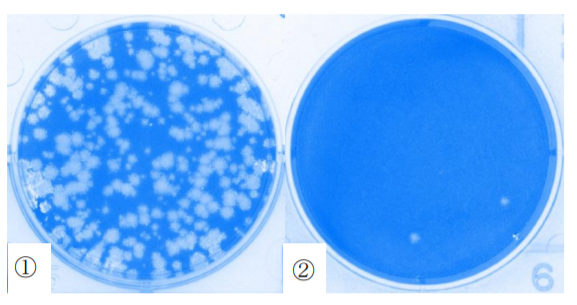
コロナウィルスの不活化

アデランスグループ「アデランスバイオ社」が製造開発した
光触媒溶剤が新型コロナウィルス99.700%不活化効果を確認

毛髪・美容・健康のウェルネス事業をグローバル展開する株式会社アデランス(本社:東京都新宿区、代表取締役社長 津村 佳宏)は、自社で製造する光触媒溶剤の新型コロナウィルスに対する不活化効果を実証するため、公立大学法人奈良県立医科大学医学部微生物感染症学講座にて試験を実施しました。光触媒溶剤を塗布したガラス板に、可視光を2 時間照射後で91.818%、6 時間で99.700%不活化することが確認できました(2021年9月)。当該溶剤は、今後アデランスバイオ社において商品化を進めてまいります。
当社では、新型コロナウィルスの流行により、衛生管理への意識が高まる中、昨年9月に、抗菌・抗ウィルス・消臭などの効果が期待される光触媒技術を用いた環境衛生事業を立ち上げ、光触媒ブランドの展開を開始しました。さらに今年3月には、光触媒技術を中心としたカーボンニュートラルに寄与する技術及び抗菌・抗ウィルスに関する技術研究、商品開発・製造等の環境衛生事業を手掛ける株式会社アデランスバイオ(本社:佐賀県佐賀市、代表取締役社長 千藤 伸一)を設立し、7月には佐賀市内に工場を竣工、8月より本格稼働を開始しています。光触媒をはじめとする衛生商品の開発製造から販売までを一貫して手掛けることで、アデランスグループ全体における環境・衛生分野の強化・推進を図ります。
工場の本格稼働に先立ち、新型コロナウィルスの不活化効果を実証するため、当社で製造した光触媒溶剤を用いて、公立大学法人奈良県立医科大学医学部微生物感染症学講座にて試験を実施しました。その結果、光触媒溶剤による、新型コロナウィルスの不活化を確認しました。今回の試験で新型コロナウィルスに対する不活化効果が実証された光触媒溶剤は、今後、アデランスバイオにおいて商品化を進めてまいります
光触媒が持つ抗菌・抗ウィルス効果によって、新型コロナウィルスの不活化効果があるか明らかにすること。
光触媒加工したガラス板(AD-SⅡ)(50 mm x 50 mm)
新型コロナウィルス(SARS-CoV-2)
• 試験は次の通り、可視光条件で実施した。
• 試験品に新型コロナウィルスを接種し、⼀定時間次の表1の条件にて静置した。
• 可視光条件は、白色蛍光灯にて可視光照射(1000 lux)とした。
• 作用時間後、PBS液によってウィルスを回収した。
• 回収液を用いてVero E6細胞に感染させ、ウィルス感染価(PFU/sample)をプラーク法にて測定した。
• 3日培養後に細胞を観察し、ウィルス感染価ならびにウィルスの不活化効果を算出した。
表1.試験品に対する作用時間
*:試験品は、試験直前まで殺菌灯に24時間照射してから使用した。
#:1000 luxは、UVカットフィルター N169(380 nm以下の波長をカット)を使用した。
〇:測定9ポイント×実施2回
◎:測定8ポイント×実施2回
試験結果を表2〜3に示した。AD-SⅡで光触媒加工したガラス板に感染価1.28 x 105 PFU/sampleの新型コロナウィルスを接種すると時間経過と共に感染価は減少し、可視光照射(1000 lux)6時間後では1.50 x 101 PFU/sample(減少率99.700%)の感染価であった。
表2.可視光条件下(1000 lux)におけるウィルス感染価の推移(PFU/sample)
表3.可視光条件下(1000 lux)におけるウィルスの不活化効果
写真①:コントロール。新型コロナウィルスが細胞に感染し、破壊した箇所が白く見える。(ウィルスが不活化していない)
写真②:光触媒加工ガラス板。新型コロナウィルスによる細胞の破壊は減少している。(ウィルスが不活化している)
本試験で使⽤した光触媒加工ガラス板は、新型コロナウィルス(SARS-CoV-2)を不活化することが判明した。本試験を用いることにより、物質の表面についた新型コロナウィルスによる接触感染防止に有効である可能性が考えられた。なお、浮遊するウィルスへの効果、人体への影響については検証を行っていない。
酸化チタンが持つ光触媒反応を応用した技術で「それ自身は変化せず、光を受けることで反応を促進するもの」と定義づけられ、光触媒を吹き付けた箇所に太陽光や室内灯などの光が当たることによって、その表面で化学反応を起こし、有機物などを分解する特徴があるとされています。室内壁面などに光触媒コーティングを施すことで、光触媒自体に付着する菌やウィルスの増殖を抑制、悪臭を緩和します。
また、太陽光や室内照明などから出る光エネルギーのみで作用が起こるため、枯渇性エネルギーを使用することなく衛生環境の維持ができるサステイナブルな技術としても注目が高まっています。
※すべての菌・ウィルスに効果があるわけではありません。
| アデランス ホームページ | https://www.aderans.co.jp |
|---|---|
| アデランス CSRホームページ | https://www.aderans.co.jp/corporate/csr/ |